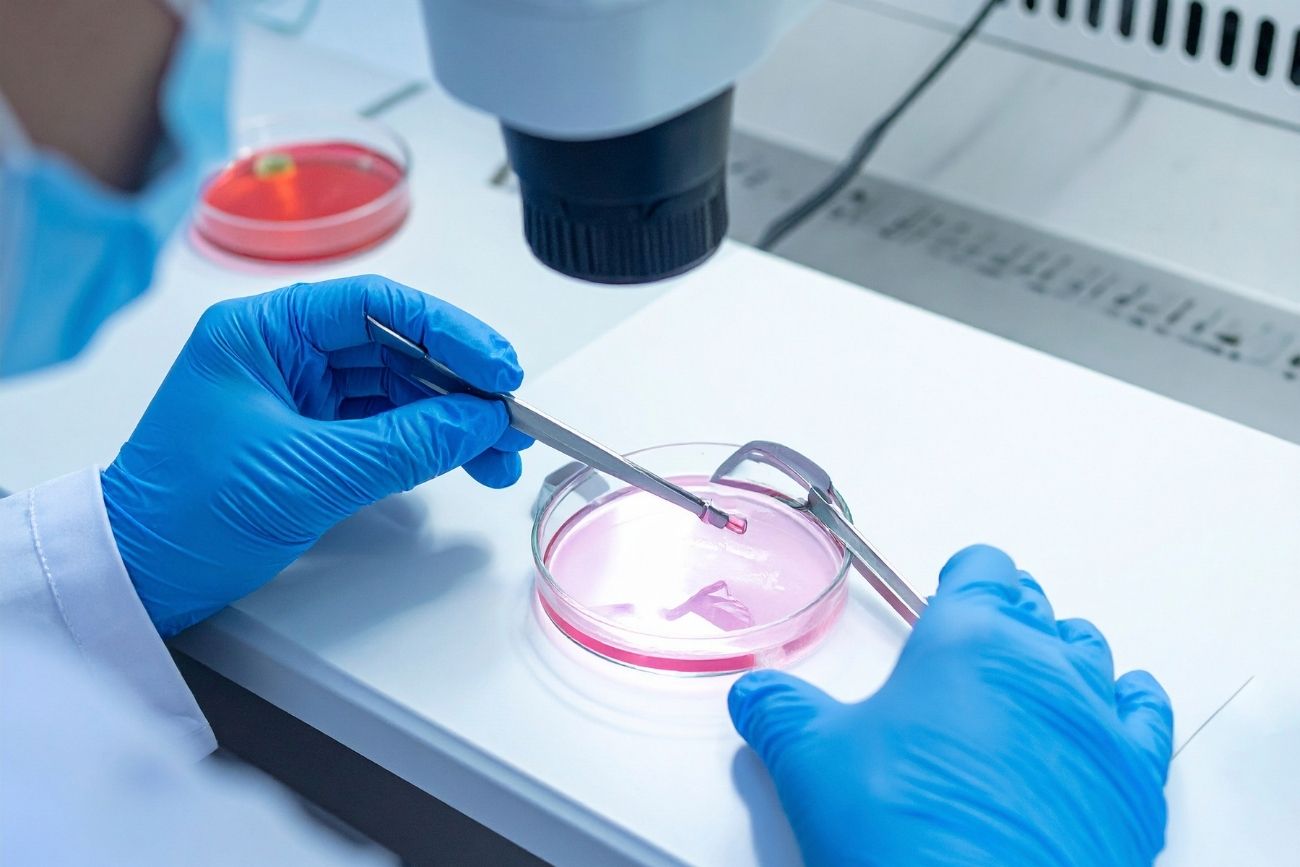

ონკოლოგიური გენომიკის სერვისები
- მთავარი
- ონკოლოგიური გენომიკის სერვისები

პრეციზიული ონკოლოგიური გენომური ტესტირება
RareGene უზრუნველყოფს ყოვლისმომცველ ონკოლოგიურ გენომურ სერვისებს, რომლებიც შექმნილია პერსონალიზებული კიბოს მკურნალობის სტრატეგიების დაგეგმვისთვის. ჩვენი ტესტირება მოიცავს სითხის ბიოფსიას (ctDNA), მოქმედი მუტაციების აღმოჩენას და მოლეკულურ პროფილირებას.
გენეტიკური ცვლილებების გამოვლენით, რომლებიც გიბერავენ კიბოს პროგრესს, ჩვენ ვეხმარებით ექიმებს მიზნობრივი თერაპიის არჩევასა და მკურნალობის ეფექტურობის მონიტორინგში.
ჩვენი მოწინავე მოლეკულური პლატფორმები მხარს უჭერს პრეციზიულ მედიცინას თანამედროვე ონკოლოგიურ მოვლაში.

ონკოლოგიური გენომიკის უპირატესობები
- მოქმედი მუტაციების გამოვლენა
- პერსონალიზებული მკურნალობის მითითებები
- მინიმალურად ინვაზიური სითხის ბიოფსიის ტესტირება
- თერაპიის უკეთესი არჩევანი
- პრეციზიული მედიცინის სტრატეგიების მხარდაჭერა
რა შედის ამ სერვისში?
- სითხის ბიოფსია (ctDNA ანალიზი)
- ტიუმორის მუტაციების პროფილირება
- მოქმედი ბიომარკერის აღმოჩენა
- მოლეკულური ონკოლოგიის ანგარიშგება
- კლინიკური ინტერპრეტაციის მხარდაჭერა
რატომ აირჩიოთ RareGene ონკოლოგიური გენომიკისთვის?
- მოწინავე პრეციზიული სექვენირების ტექნოლოგია
- მაღალი სენსიტივობის მუტაციების აღმოჩენა
- კლინიკურად გამოყენებადი ანგარიშგება
- სანდო შედეგების მიღების დრო
- საერთაშორისო ხარისხის სტანდარტების დაცვა
შენიშვნა:
ონკოლოგიური გენომური ტესტირება მხარს უჭერს მკურნალობის დაგეგმვას და უნდა ინტერპრეტირდეს კლინიკური ონკოლოგიური შეფასების კონტექსტში.
